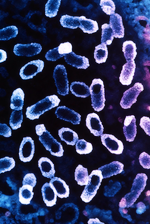
Ideal Infection

WBN USA Edition
WBN – USA Edition brings AI-powered business news, trade updates, and growth tools to help American entrepreneurs lead, adapt, and succeed in a fast-changing economy.

A growing number of workers are redefining success through meaning, autonomy, and purpose—not promotions. Companies that treat fulfillment as a strategic asset, not a perk, will lead the future of work.
by Wendy S Huffman & WBN News Global & WBN News Nashville & WBN USA Edition
If we want to change what we see, we don’t start by changing the world. Instead we change our lens.
by Les Mottosky & WBN News Canada & WBN News Global & WBN News Okanagan & WBN News Nashville & WBNNewsCalgary & WBN USA Edition & WBN News Winnipeg & WBN News Europe & WBN News Africa & Westcoast German News
Most business mistakes stem from internal data mismanagement, not external forces. GDPR isn’t just a regulation—it’s a strategic playbook for digital trust, clarity, and growth.
by Gianni Dell'Aiuto & WBN News Global & WBN USA Edition & WBN News Nashville
One of the most profound influences on our vitality and longevity is an organ few of us consider an organ
by Les Mottosky & WBN News Canada & WBN News Global & WBN News Okanagan & WBN News Nashville & WBNNewsCalgary & WBN USA Edition & WBN News Winnipeg & WBN News Europe & WBN News Africa
Is there a reason we repeat learnings? And do we need to shame ourselves when it happens? Children don't. Toddlers ask “why?” 300 times a day, get the answer, forget it, ask again tomorrow.
by Les Mottosky & WBN News Global & WBN News Canada & WBN News Okanagan & WBN News Nashville & WBNNewsCalgary & WBN USA Edition & WBN News Winnipeg & WBN News Europe
Questioning anything: decisions, patterns, intentions, and experiences with the sincerity and intensity of a child sets us on a path of learning that can otherwise get obscured in the busyness of living.
by Les Mottosky & WBN News Global & WBN News Canada & WBN News Okanagan & WBN News Nashville & WBNNewsCalgary & WBN USA Edition & WBN News Winnipeg & WBN News Europe
This rise of human hubris is the first indication that a transformation is incoming and the restoration of balance is sure to follow.
by Les Mottosky & WBN News Global & WBN News Canada & WBN News Okanagan & WBN News Nashville & WBNNewsCalgary & WBN USA Edition & WBN News Winnipeg & WBN News Europe
You don’t need to do all the convincing yourself. User-generated content gives your audience social proof that builds trust and drives conversions.
by Susie Taylor & WBN News Canada & WBN News Global & WBN USA Edition

